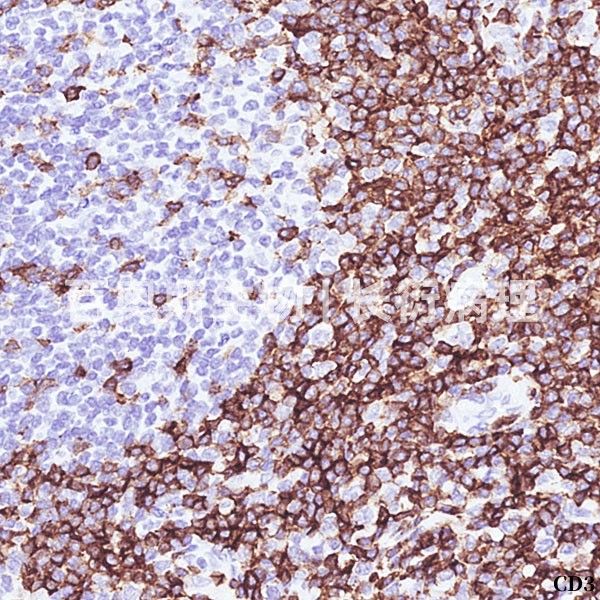
病理学实验技术服务

全脑c-Fos免疫荧光染色 小鼠全脑组织透明化三维成像
离体组织透明三维成像技术服务: 通过将佳维斯自主研发的离体透明技术和三维成像技术相结合,可获得各类组织器官内血管、神经、细胞、蛋白等高分辨三维整体影像结果。如心、肝、脾、肿瘤等所有组织器官,通过组织透明技术结合三维成像,可在不切片的条件下,直接获得其完整组织的高分辨结果,可替换传
地区:武汉服务名称:组织透明化三维成像

NAB2重组蛋白表达
分析:mRNA、密码子偏爱性等多维度优化。2. 多种表达载体和宿主菌供选择。 服务内容 价格 周期 交付标准 备注 基因优化合成 市场优惠时价 含合成基因质粒和克隆菌 蛋白表达 *验证测试 500元 5个工作日 含目的基因的表达质粒+克隆菌株+表达菌株 *表达保证型 2000元 1
服务名称:重组蛋白表达提供商:福因德科技(武汉)有限公司

999元享多抗定制超值服务
活动时间:2020年5月15-2020年6月15 活动规则: 1、定金1元,3人成团,即可享多抗定制999元超值服务。 2、客户提供抗原,免疫交付所有血清,常规抗原效价不低于1:100000,特殊抗原请详询。 3、此活动最终解释权归武汉金开瑞生物工程有限公司所有。 关于金开瑞抗体
地区:武汉服务名称:999元享多抗定制超值服务
¥3000-10000

Human PTGIR重组蛋白表达
receptor, PGI2 receptor, Prostanoid IP receptor服务内容:服务项目客户提供服务内容服务周期交付内容大肠杆菌系统蛋白表达基因序列方案沟通1天方案报告密码子优化和基因合成5天基因合成报告表达纯化测试3天表达纯化测试报告1L表达及纯化3天蛋
文献支持地区:湖北省武汉市服务名称:大肠杆菌系统重组蛋白表达

磷酸化抗体定制服务 TD-P-02
磷酸化抗体定制服务 货号:TD-P-02 天德生物公司提供的磷酸化抗体定制服务包括: 多肽抗原设计,偶联,免疫,抗原亲和纯化. 最终交付的抗体将通过磷酸化多肽与非磷酸化多肽的双重检测确认,确保质量合格。 磷酸化抗体可以特异性识别磷酸化的氨基酸位点。磷酸化抗体可以用于区分蛋白质的磷酸
地区:武汉服务名称:磷酸化抗体定制服务

CX3CR1-GFP 杂合子小鼠
Cx3cr1位于小鼠的9号染色体,采用CRISPR/Cas技术,设计sgRNA,通过应用高通量电转受精卵方式,获得Cx3cr1基因敲除小鼠,性成熟后取精子冻存。
提供商:鼠来宝生物

肺缺血再灌注-肺损伤模型
本司通过血管夹夹闭左肺门(包括动脉、静脉和左主支气管)- -段时间后松开, 使血液再灌注,构建肺缺血再灌注模型造模周期为一周。 背景:肺缺血再灌注损伤(Pulmonary ischemia reperfusion)是由于机体组织或器官在缺血再灌注后导致肺组织迅速损伤,缺血再灌注可能
地区:武汉服务名称:肺缺血再灌注-肺损伤模型构建
¥650-700

双荧光素酶实验
原件的影响。为避免由于质粒转染细胞时效率差异所造成的误差,通常会转入Renilla luciferase的报告基因质粒作为内参(最强波长在465nm左右),即双荧光报告系统。 实验流程 (1) 用生物信息学方法分析并预测启动子区可能的转录因子结合位点。 (2)设计引物用PCR法从基
地区:武汉服务名称:武汉傲星生物科技有限公司
¥1000-10000

重组蛋白表达|病毒样颗粒 (VLPs) 技术平台/去垢剂技术平台/Nanodisc技术/ Nanoparticle技术
)的基础上,经过不断探索与优化,华美生物现已推出四大优势药靶蛋白表达平台,分别是病毒样颗粒 (VLPs) 技术平台、去垢剂技术平台、Nanodisc技术平台和Nanoparticle 表达平台。 ● 阳性抗体制备 阳性抗体又称药物对照抗体,阳性抗体序列参考优先次序依次为:已上市的抗
地区:CN服务名称:先导抗体分子发现服务
¥1-99999

动物组织Micro-CT扫描服务/高分辨率显微CT检测服务
CT成像的原理是当X-射线透过样本时,样本的各个部位对X-射线的吸收率不同。X-射线源发射X-射线,穿透样本,最终在X-射线检测器上成像。对样本进行360°以上的不同角度成像。与临床CT普遍采用的扇形X线束不同的是,Micro-CT通常采用锥形X线束。采用锥形束不仅能够获得真正各
地区:武汉服务名称:Micro-CT扫描服务
¥200-700

谱度众合护航科研成果:2025年高分服务案例覆盖多热门研究方向
2025 年谱度众合的科研服务战绩堪称 “高分收割机”!我们助力合作客户拿下超 30 篇影响因子≥10 分的顶刊成果:从 IF=33 的《Journal of Hepatology》(Q1 / 医学 1 区),到 IF=27.7 的《Nature Immunology》(Q1 /
¥1500-1800
病理学实验技术服务
病理学实验技术服务 唯一能够提供全套专业病理实验技术服务的公司: 知名医院专业病理医生、病理学博士技术支持; 技术人员由知名病理科技术专家提供培训指导; 可开展全套病理实验技术服务包括组织处理、脱水、包埋、切片及后续染色、病理读片分析等一站式服务。 核心优势: 专业的团队:医学博士
地区:全国服务名称:病理学实验技术服务
¥5-50

课题实验/实验设计/整体实验外包
可靠的实验软硬件。积极开展与科研单位和个人的科研课题合作,与国内多家科研院所、各级医疗单位等建立了广泛的合作关系。 不论您是整体课题项目还是单独实验项目,柏迈德BioMed均可为您提供全程技术服务,为您大大节省科研成本和缩短课题时间,并提供科研支持咨询(如实验设计方面的评估与修改)
地区:全国服务名称:课题实验,实验设计,整体实验外包
¥2000-20000

天车定位系统供应商
、机械系统等有轨搬运设备精确定位和自动控制,包括:环形炉定点加热、环冷小车定位(硅钢厂、烧结厂);卸料小车定位(矿山、烧结、球团、原料、焦化、炼铁、港口、石灰窑);天车定位(冷轧、热轧、剪切库、板坯库、钢卷库、成品库、原料库、垃圾发电厂、矿热炉车间料罐倒运、垃圾发电厂);推拨车机迁
地区:武汉提供商:武汉索尔德
¥50000-100000

fMOST三维成像服务
关于MOST 显微光学切片断层成像(Micro-Optical Sectioning Tomography,MOST)和荧光显微光学切片断层成像(fMOST)系列设备能对生物大样本进行亚微米水平三维成像,不仅可以获得单细胞分辨的全脑神经连接图谱、定位神经环路、追踪单神经元长程投射
文献支持地区:武汉服务名称:fMOST亚微米级三维成像技术服务
¥10000-50000

Real-time Quantitative PCR(qPCR)
分类:根据荧光标记不同分为SYBR Green嵌合法和Taqman探针法。 根据检测内容不同分为相对定量PCR和绝对定量PCR。
¥90-150

饲料、垫料及笼具
)纯化饲料 240¥/kg 饲料 MD12033(60 kcal%fat 高脂)纯化饲料 260¥/kg 饲料 定制饲料(根据客户提供的配方加工) 按配方收费 垫料 普通杨木垫料(4kg/袋) 40¥/袋 垫料 普通玉米芯垫料(20kg/袋) 100¥/袋 笼器具 开放式笼具 询价
地区:武汉简介:饲料、垫料、笼具
¥40-280

维D代谢谱
项目背景 维生素D(Vitamin D, VDs)是一种必需的脂溶性维生素 ,也是固醇激素合成的前体。主要形式为维生素D2(麦角钙化醇)和维生素D3(胆钙化醇)及经过两者代谢合成的一系列衍生物。它在调控体内钙磷水平和矿化骨骼上有重要作用,而且对骨外系统,包括心血管系统、糖代谢、免
文献支持地区:全国服务名称:维D代谢谱
¥300-1500

tunel染色(荧光)
(fluorescein-dUTP) ,从而可以通过荧光显微镜或流式细胞仪进行检测,这就是TUNEL (TdT-mediated dUTP Nick-End Labeling) 法检测细胞凋亡的原理。
地区:武汉服务名称:tunel染色(荧光)
¥180-220

肺克ATCC700603
微生物转座子突变体构建和鉴定服务 本公司提供细菌转座子突变体库构建和鉴定服务,以及标准株突变体现货库: 现货库包括(货期1个月): 铜绿假单胞菌PAO1,PAK 大肠杆菌ATCC25922 肺克ATCC700603 幽门螺杆菌ATCC26695,ATCC43504,SS1 金色葡
文献支持地区:湖北武汉服务名称:微生物转座子突变体构建和鉴定服务 本公司提供细菌转座子突变体库构建和鉴定服务,以及标准株突变体现货库
¥5000-50000












